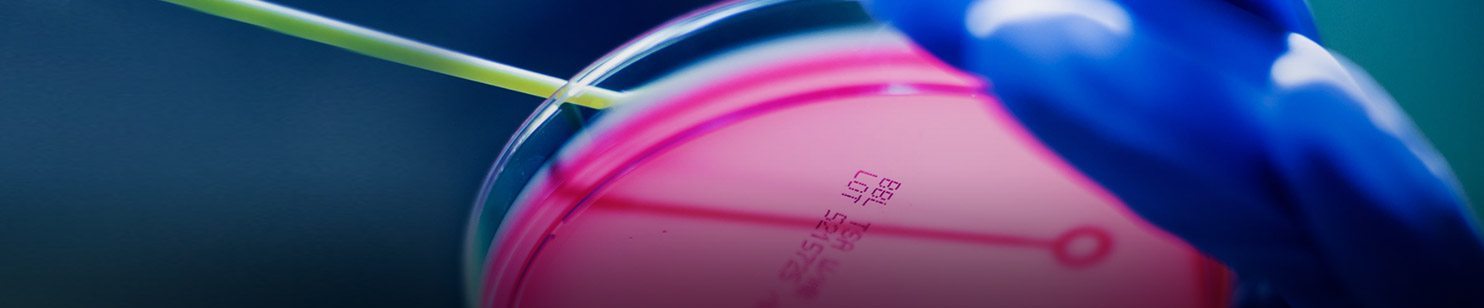

Newfoundland and Labrador - a rare find
Biotechnology
A strong applied research sector has grown around our academic institutions. Our unique population genetics, along with collaborative relationships between government, health authorities, and researchers, have led to significant breakthroughs in genetics. Our researchers have discovered the gene for sudden cardiac death and developed a test to detect it, along with ways for patients to mitigate the risks of the gene. There have also been discoveries around hearing loss in children, with broad implications for those with hearing impairment. Significant public and private investments, along with a cluster of researchers, make the province an attractive location to conduct genetic research and develop health informatics applications.
Programs
Industrial Research Assistance Program
The National Research Council provides financial support for qualified small and medium-sized enterprises (SMEs) in Canada to undertake technology innovation.
Learn More
Research and Development Funding
Funding for commercial, academic, and student research and development, ranging from proof of concept to commercialization.
Learn More
SUPPORT Program
As a public-private partnership, the SUPPORT (SUpport People and Patient-Oriented Research and Trials) Program was developed to improve healthcare outcomes. The program brings together the MUN Faculty of Medicine, Canadian Institutes of Health Research (CIHR), the government of Newfoundland and Labrador, IBM, and other provincial and federal agencies.
Learn More
Business Investment Fund
Offered by the Government of Newfoundland and Labrador to small and medium-sized enterprises (SMEs) operating within the province to increase their productivity and improve their competitiveness.
-
100s of Researchers
-
World-class Research Centres
-
Strong Public, Private, and Academic Partnerships
-
Unique Genetic Composition of Population